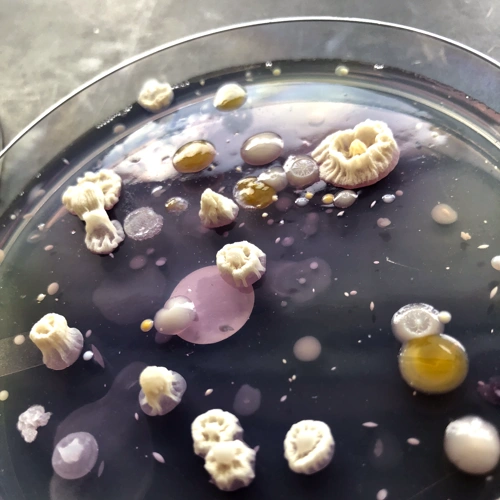
Picture of microbes on an agar plate

Applied Food Microbiology and Safety Laboratory
Microbial challenge studies reflect guidelines developed by the National Advisory Committee on Microbiological Criteria for Foods. Data derived from well-designed and implemented studies are used by manufacturers to modify formulation, processing, cooking instructions, and storage time and temperatures, and to identify limits for critical control points.
Research is funded through sponsored research agreements with individual food companies and industry consortia, competitive federal grants, and unrestricted gifts by FRI sponsors. Projects are conducted and supervised in collaboration with FRI Executive Committee and Affiliated Faculty and coordinated by the Applied Food Safety Laboratory Director
Facilities and Research Information
- Microbiology laboratories in the Sciences building (MSB)
- BSL-2 food processing laboratory at MSB
- Equipment such as steam-jacketed cookers, mixers, grinder, slicer, stuffer, combioven, grill, deep-fat fryer, vacuum and modified-atmosphere packaging equipment, cheese vat
- Meat processing facility at the Meat and Muscle Biology Laboratory.
Cindy Austin, (608) 219-1424, cbaustin@wisc.edu
- Dairy processing facility at the UW-Madison Babcock Hall
- Foodborne pathogens
- Clostridium botulinum, Clostridium perfringens, Bacillus cereus and other sporeformers
- Listeria monocytogenes,Staphylococcus aureus
- Salmonella, E. coli O157 and other shiga-toxin producing E. coli
- Includes an extensive collection of food, clinical, and environmental isolates
- Shelf-stable and refrigerated foods
- Process cheese products, natural cheese, cultured dairy products
- Fermented, dried, and high-moisture ready-to-eat meat and poultry products
- Refrigerated convenience foods, deli salads
- Bakery products
- Understanding the role of competitive microbiota and shelf-life in evaluating the safety of foods
- Understanding microbial adaptation to stress conditions found in foods and processing environment
- Understanding practical manufacturing variation and limitations in daily food production
- Validating the thermal inactivation of Salmonella in baked goods, seeds, and nuts
- Control of non-O157 shiga-toxin producing E. coli in pepperoni processing
- Improving the control of C. botulinum and L. monocytogenes on ready-to-eat processed meats using "natural" antimicrobials and curing systems
- Formula modifications to control C. botulinum, S. aureus, and L. monocytogenes in pasteurized process cheese and related products (hot-filled and post-process contamination)
- Formula modifications to control L. monocytogenes in processed meat and poultry products
- Effect of cooling rate and antimicrobials on microbiological safety of cultured dairy products
- Supporting documentation for Food Code variances for refrigerated storage of low-acid foods.
- Control of Clostridium perfringens, Bacillus cereus, and Clostridium botulinum during extended cooling of meats and process cheese.
- Determination of D and z-values for Listeria monocytogenes and Salmonella in plant based process cheese analog
- Evaluation of clean label preservatives on the inhibition of vegetative and sporeforming foodborne pathogens in RTE meats
- Enumeration of sulfite reducing clostridia and Clostridium botulinum in powdered infant formula
For information about sponsored projects, proposals and budgets, or to schedule a project, contact Kristin Schill at (608) 264-1368 or kristin.schill@wisc.edu or any of the FRI faculty. Priority access is given to FRI Sponsor Organizations.